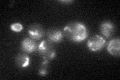

View description
Mitochondrial matrix iron chaperone; oxidizes and stores iron; interacts with Isu1p to promote Fe-S cluster assembly; mutation results in multiple Fe/S-dependent enzyme deficiencies; human frataxin homolog is mutated in Friedrich's ataxia
Localization:
Intensity:
Fold change:
Significance:
-
C’ GFP library in SD

mitochondria36.99 -
N' NOP1pr-GFP in SD

mitochondria151.448 -
N' TEF2pr-mCherry in SD

mitochondriaN/A -
N' NATIVEpr-GFP in SD

mitochondria69.6597 -
N' TEF2pr-VC and Cyto-VN in SD

#N/A0 -
C’ GFP library in SD+DTT

mitochondria37.41.01No -
C’ GFP library in SD+H2O2
mitochondria36.060.97No -
C’ GFP library in Starvation Media

mitochondria35.420.95No -
C’ GFP library on the background of Pup2-DaMP

N/A -
C’ GFP library on the background of CCT mutant

N/A0N/AYes
